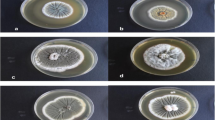

Abstract
Isaria fumosorosea frequently causes mycosis of agricultural pests in the hot semiarid and dry tropical regions of Mexico. Because temperature tolerance restricts the use of fungal biopesticides, we investigated two isolates from these areas for possible development into mycoinsecticides for use in hot weather agricultural zones. We studied the effects of culture system (solid or submerged cultures) and temperature on the fungal growth, extracellular enzyme production, pathogenicity, and thermotolerance of the produced propagules. Between 20 and 28 °C, the specific growth rates of the isolate PCC were higher on solid media, but in the submerged culture, the isolate P43A grew faster even at temperatures of up to 34 °C. On solid media, P43A produced 1.5-fold more proteases than PCC, but in the submerged culture, both strains had similar activities. Under the same culture conditions, PCC produced a blastospore:conidia ratio of 1:2, and P43A produced a ratio of 1:5. PCC aerial conidia had the shortest Lethal Time 50 (LT50, the time to reach 50 % mortality) against Galleria mellonella larvae, but LT50 was equal for the aerial conidia and the submerged propagules of P43A and PCC. The submerged and aerial propagules of P43A were more thermotolerant than those of PCC. Each isolate performed differently in each culture system, and we concluded that the intended production method should be included as a criterion for screening of entomopathogenic fungus. We found that thermotolerance is a specific characteristic of an isolate from a given species. Because of its specific characteristics, P43A shows more promise for the development of a submerged conidia-based mycoinsecticide for foliar application in aqueous form in hot climate regions.
Similar content being viewed by others
Avoid common mistakes on your manuscript.
Introduction
Mycopesticides are products based on living fungal propagules and are intended to control agricultural pests. In recent studies, the effects of these propagules in termites, arthropods, bovine tick and disease vectors have been explored (Brand et al. 2010; Fernandes et al. 2012; Howard et al. 2011). The following types of propagules are produced by fungus: hyphae, blastospores and aerial or submerged conidia (the last three types listed may be known as spores). Among the mycopesticides that are currently registered, undergoing registration or marketed, about 6 % are based on Isaria species (previously known as Paecilomyces) (de Faria and Wraight 2007). These species have diverse insect hosts and are able to control Bemisia species, which are some of the most damaging whitefly pests to economically important crops (Lacey et al. 2008; Wraight et al. 2007).
The process of identifying an appropriate fungal isolate for development as a mycoinsecticide is complex. It is important to consider the feasibility of mass production of stable propagules. Furthermore, we must account for the environmental conditions that coincide with the need for insect control; weather conditions, particularly temperature and radiation during the crop cycle, are important because temperature tolerance is a critical abiotic factor that restricts the use of fungal biopesticides (Imoulan et al. 2011; Jackson et al. 2010). Most entomopathogenic fungi have a wide temperature tolerance (from 0 to 40 °C), but the optimal temperature for spore germination and growth is between 23 and 28 °C. The most favorable temperature for infection is between 20 and 30 °C. In general, the growth of most isolates slows down above 30 °C and ceases above 34 °C. Similarly, spore germination is adversely affected by temperatures over 30 °C. Measuring the influence of temperature on growth is a logical starting point in the development of a new fungal isolate for use as a microbial control agent (Cabanillas and Jones 2009; Jaronski 2010; Shoaib et al. 2011; Wraight et al. 2007). Because Isaria species are predominantly found in the tropics and subtropics, they may be suitable for development into products for use for hot climate regions.
The primary infective form of most fungal entomopathogens is the aerial conidium, and solid state fermentation is widely used for production (Jackson et al. 2010). In Latin American countries, mycoinsecticides production facilities mostly produce conidia in bags of moistened grains (typically rice or wheat). In submerged cultures, many of these fungi produce submerged conidia, sclerotia and single cells known as blastospores (or hyphal bodies) from the hyphae via a yeast-like budding process (Vega et al. 2003; Vidal et al. 1998). Blastospore-based mycoinsecticide are currently produced commercially from Lecanicillium lecanii and I. fumosorosea, but submerged conidia have not yet been commercially developed as biological agents to control insects. Characteristics including hydrophobicity, temperature tolerance, desiccation tolerance and the germination rate are different for aerial conidia, submerged conidia, blastospores and sclerotia. Therefore, the mycoinsecticides based on these various propagules are intended for different applications (Jackson et al. 2010).
Unlike most other pathogens, which need to be ingested, fungi generally infect insects by actively penetrating the cuticle using a combination of mechanical pressure and enzymatic degradation (Ali et al. 2010; Montesinos-Matías et al. 2011; Zibaee et al. 2011). This process has been primarily attributed to the hydrolytic enzymes that are expressed by the germination conidia (El-Sayed et al. 1993; Rodríguez-Gómez et al. 2009). Ali et al. (2009) considered that fungal isolates with high germination rate and high hyphal growth rates are advantageous for biological control because they could quickly infect the host. The insect integument is a barrier against invading microorganisms and is composed of proteins, chitin, associated lipids and phenolic compounds (Hegedus and Khachatourians 1988). Through the combined action of hydrolytic enzymes (such as chitinase, protease and lipase), the fungal mycelia are able to penetrate the host barrier and infection occurs (Ali et al. 2009). Because proteins may account for up to 70 % of the cuticle, proteases play a major role in the penetration process (Ali et al. 2010; Montesinos-Matías et al. 2011).
Since Isaria fumosorosea frequently causes the mycosis of agricultural pests in hot weather regions in Mexico, isolates from these areas may have potential for development into biocontrol products for these agricultural zones. When designing a new process for large-scale production of microbial cells, the utility of different culture systems must be taken into account. Therefore, we aim to determine whether I. fumosorosea isolates from hot climate agricultural areas behave in similar manners when they are produced via solid or submerged fermentation. Furthermore, we seek to determine whether the propagules produced using these culture systems are thermotolerant and pathogenic.
Materials and methods
Fungal isolates
Two isolates of I. fumosorosea from México were used in this study. Strain P43A was isolated from Planococcus ficus (Signoret) from vineyards located in Villa Pesqueira, Sonora, Mexico (29°22′15′′–29°22′57′′N and 110°54′15′′–110°53′39′′ W, 634 m above sea level). Villa Pesqueira has a hot, semi-arid climate with an average annual precipitation of 508 mm and temperatures of up to 47 °C in the summer (http://smn.cna.gob.mx/). Strain PCC was obtained from Agrobiologicos de Sinaloa S.A., it was isolated from Diaphania sp (Lepidoptera: Pyralidae) from the Culiacan Valley, in Sinaloa, México (24°54′10′′–24°27′56′′ N and 107°21′50′′–107°50′15′′ W, 54 m above sea level). The Culiacan Valley has a dry, tropical climate with temperatures of up to 43 °C in the summer and an annual precipitation of between 600 and 800 mm (http://smn.cna.gob.mx/). Both strains were identified at the Centro Nacional de Referencia de Control Biológico (Mexico). Monosporic cultures of each strain were cultivated on Sabouraud-dextrose agar with yeast extract (Difco, MD). After sporulation, cylinders of 1.0 cm diameter were preserved in vials with 10 % glycerol at −20 °C.
Culture media
Rice agar
Rice was washed with tap water, dried at room temperature and milled in a blender. A total of 12 g was sterilized in 90-mm-diameter Petri dishes at 121 °C for 2 h. Sterile 1.5 % agar and 1 % yeast extract were added to the rice.
Sabouraud-dextrose agar with yeast extract (SDAY)
SDAY (Difco, MD) was supplemented with 1 % yeast extract (Difco, MD) and sterilized at 121 °C for 15 min.
Sabouraud-dextrose broth (SDB)
The medium was composed of 5 g/l tryptone (Difco, MD), 5 g/l bactopeptone (Difco, MD) and 20 g/l dextrose. The pH of the medium was adjusted to 5.7 ± 0.2 prior to sterilization at 121 °C for 15 min.
Minimal medium
The medium was composed of 1 l of deionized water and 50 g of dextrose, 2 g of NH4NO3, 2 g of KH2PO4, 2 g of KCl, 0.2 g of MgSO4·7H2O, 20 mg of ZnSO4·7H2O, 20 mg of FeSO4 7H2O and 15 mg of CuSO4·5H2O. The pH of the medium was adjusted to 5.0 prior to sterilization at 120 °C for 15 min. For enzyme production, 1 % casein or 2 % olive oil was added instead of dextrose. The solid media for enzyme production was prepared according to that described by Hankin and Anagnostakis (1975).
Solid and submerged cultures
Rice-agar plates were inoculated from the frozen cell stocks of each isolate and then incubated at 28 ± 1 °C in the dark until mycelia covered the plate. The plates were then exposed to daylight at 25 ± 1 °C until sporulation. The aerial conidia were collected using 0.05 % Tween 80, and the spore suspension was adjusted to a concentration of 1x106 conidia/ml for the inoculation of the flasks or plates.
Solid culture
To evaluate the effect of temperature on fungal growth, 3 μl of the aerial conidia suspension (1 × 106-conidia/ml) was transferred onto the center of a 90-mm-diameter sterile SDAY plate. After the suspension had dried, two perpendicular straight lines were drawn on the bottom of each Petri dish (the lines intersected at the center of the drop of the suspension). The plates were incubated at 20, 23, 25, 28, 30, 32 or 34 ± 1 °C. The diameter of each colony at its intersection with each perpendicular line was measured every 12 h with a Truper Digital Caliper (Model CALDI-6MP) (Esteves et al. 2009; Miyashira et al. 2010). The experiments were performed three times, and the specific growth rate (μ) was calculated using the exponential growth model.
Submerged culture
Erlenmeyer flasks (125 ml) containing 20 ml of SDB medium and 20 μg/ml of gentamicin were inoculated with the aerial conidia suspension to a final concentration of 1 × 106 conidia/ml. The flasks were incubated at 20, 23, 25, 28, 30, 32 or 34 ± 0.5 °C with oscillatory shaking at 180 rpm (New Brunswick scientific Co. Inc., series 25). A total of three flasks were removed when a sample was required. Fermentations were also performed in a 3 l stirrer-tank reactor (Autoclavable Bio Reactor System, Applikon Biotechnology) using the minimal medium. The reactor operated under the following conditions: 1.5 l working volume, 28 °C, aeration rate of 0.33 vvm, and stirrer speed of 600 rpm. Dissolved oxygen was maintained between 60 and 65 % over the saturation level by enrichment of the air flow with pure oxygen, and the pH was controlled to 5 ± 0.1 using 2 M NaOH. The reactor was inoculated with the aerial conidia suspension to a final concentration of 7 × 105-conidia/ml. The experiments were performed three times.
Thermotolerance of aerial conidia and submerged propagules
Aerial conidia were collected from SDAY-Petri dishes using 0.05 % sterile-Tween 80. Submerged propagules were produced in the bioreactor in minimal medium at 28 °C. The fermented broth was filtered once through a sterile double layer of cheesecloth to remove mycelia. Vials of 20 ml containing 1x108 cell/ml of aerial conidia or submerged propagules were treated at 30, 32, 34, 38 or 42 ± 0.1 °C for 30 min. Afterward, the total content of each vial was inoculated into a 125 ml-Erlenmeyer flask containing 20 ml of minimal medium with 5 g/l yeast extract and then incubated in an oscillatory shaker at 28 ± 0.1 °C. Samples were withdrawn each hour, and germinated propagules were counted in a Neubauer hemocytometer using a light microscope (400× magnifications). Germination was deemed to be positive when a germ tube projecting from the spore was observed. The experiments were performed three times.
Enzymatic assays
Solid culture
The fungal isolates were cultivated in the media described by Hankin and Anagnostakis (1975) for 5 days at 25 °C to induce the expression of chitinase, lipase and protease. The enzyme activities were calculated as an index of the total diameter of the colony plus the clear zone surrounding it divided by the diameter of the colony (St. Leger et al. 1997).
Submerged culture
In the minimal medium, glucose was substituted with either 2 % olive oil or 1 % casein to induce the expression of lipases and proteases in a total volume of 200 ml of medium in an Erlenmeyer flask (500 ml). The pH of the medium was adjusted to 5.0 prior sterilization at 120 °C for 15 min, and 20 μg/ml of gentamicin was added after sterilization (Pogori et al. 2008; Nieto and Ellis 1986). The flasks were inoculated with the conidia suspension to a final concentration of 1 × 106 conidia/ml and incubated at 25 °C with oscillatory shaking at 180 rpm (New Brunswick Scientific Co. Inc., Series 25). Aliquots of 4 ml were taken at 0 h and then every 24 h. The samples were centrifuged at 10,864g at 5 °C for 15 min (Allegra™ X-22R Centrifuge, Beckman Coulter). The supernatants were then stored at 5 °C. Complete experiments and the determination of enzymatic activity in each sample were conducted three times. The cumulative enzymatic activity was reported as the integrated area of activity from the time of detection to the time of maximal activity.
Protease assay
The protease activity of the culture supernatant was assayed according to García-Carreño et al. (1994). The specific activity unit of the protease was defined as the amount of enzyme necessary to increase the OD at 366 nm by 0.01 absorbance unit per minute.
Lipase assay
The lipase activity was determined using p-nitrophenyl palmitate (pNPP) according to Berekaa et al. (2009). The specific activity unit of lipase was defined as the amount of enzyme necessary to release 1 μmol p-nitrophenol from the substrate per minute.
The cumulative enzyme activity in the submerged culture was reported as the integrated area of activity from the time of detection to the time of maximal activity.
Insect bioassay
Last instar Galleria mellonella larvae (Lepidoptera: Pyralidae) were disinfected in 10 ml of 70 % ethanol for 10 s and then blotted with sterile paper towels. A total of 10 larvae were immersed in a 1 × 108 conidia/ml suspension in 0.05 % Tween 80 for 20 s; the suspension contained either the aerial conidia produced on rice-agar or the submerged propagule (conidia and blastospores) produced in the minimal medium. The control larvae were submerged in 0.05 % Tween 80 or minimal medium solution. The insects were then deposited on 90-mm-diameter Petri dish containing a piece of wet cotton and a previously sterilized diet and incubated at 25 °C. Each treatment was repeated three times. The mortality was recorded every 24 h over 12 days as recommended by Tefera and Pringle (2003). To estimate the time at which 50 % of the population was killed (LT50), probit analysis was used (Kalbfleisch 1985).
Analytical methods
Biomass assay
Biomass in the submerged culture was determined by gravimetric analysis after filtration of the sample through pre-weighed nitrocellulose filters (45 mm diameter, pore size 0.45 μm). Samples were rinsed twice with 10 ml distilled water aliquots and dried at 95 °C. Each analysis was performed three times.
Submerged propagules concentration
Blastospores plus submerged conidia were counted in a Neubauer hemocytometer using a light microscope (400× magnifications) after filtering the sample through gauze to remove mycelia. Blastopores and submerged conidia were differentiated by their morphological characteristics (Vidal et al. 1998). Three samples of each experiment were counted; each count performed done three times.
Statistical analyses
For each strain in a solid or submerged culture, a one-way ANOVA was used to examine the effect of temperature on the specific growth rate (μ), germination and the LT50 values. RCBD (randomized complete block design) was used to analyze the effect of temperature on the growth rate of each strain in a liquid or a solid culture and to determine the differences between the specific growth rates and the enzymatic activities of each strain on different substrates. Tukey’s Honestly Significant Differences Test was used for all post hoc testing, and p < 0.05 was accepted as the threshold for statistical significance. SPSS Statistics Software version 17.0 was used for all the statistical analyses.
Results
Effect of the temperature on growth and thermotolerance
Solid culture
In the solid culture, PCC had a higher μ than P43A for temperatures between 20 and 28 °C, but the μ of P43A was higher at 32 °C. The optimal temperature for growth was 25 °C for both strains, but the temperature had a greater effect on the μ of the PCC strain than that of on the P43A strain (Fig. 1). The μ of the PCC strain was 1.4-fold higher than that of the P43A strain at 20 °C and 1.8-fold higher at 25 °C, while the μ of the P43A strain was twice that of the PCC strain at 32 °C.
Specific growth rates of Isaria fumosorosea isolates in solid and submerged cultures. (open circle) P43A Aerial conidia, (open square) PCC Aerial conidia, (filled circle) P43A Submerged propagules, (filled square) PCC Submerged propagules. Error bars represent standard deviations (based on three replicates)
Submerged culture
In the SDB-submerged culture, both strains were able to grow in temperature ranging from 20 to 34 °C, and the optimal growth temperature for both was 28 °C (Fig. 1). Nevertheless, at this temperature, the specific growth rate of P43A (μ = 0.3674 h−1) was 1.4-fold higher than that of PCC (μ = 0.2573 h−1). The μ of both strains in the range of temperatures assayed was higher in the submerged culture than in the solid culture. The μ of the PCC strain in the submerged culture at the optimal temperature (28 °C) was 8.8-fold higher than that in the solid culture, while for the P43A strain; the μ at the optimal temperature was 22.3-fold higher in the submerged culture than in the solid culture. Both strains formed pellets at temperatures equal to or higher than 30 °C in SDB. Maximal biomass was 4.5 g/l for both isolates, and the biomass yield on glucose was 0.22.
In the minimal medium at 28 °C, the μ was lower than that in the SDB-medium; the μ values were 0.1177 h−1 and 0.0870 h−1 for P43A and PCC, respectively. The PCC cultures contained 33.3 % blastospores and 66.7 % conidia, while the P43A cultures had 15.6 % blastospores and 84.3 % conidia.
Thermotolerance
Aerial conidia were more thermotolerant than submerged propagules. It is noteworthy that 100 % of the aerial conidia of P43A were able to germinate after 30 min at 42 °C, while only 54.3 % of the PCC-conidia germinated. Heating to 30 and 34 °C did not affect the germination of the submerged propagules of either isolate, and P43A propagules tolerated temperatures of 38 and 42 °C well. The temperature at which 50 % of spore germination was inhibited was 45.56 ± 0.21 and 43.71 ± 0.24 °C for aerial conidia and submerged propagules of P43A, respectively, and 41.93 ± 0.15 % and 39.37 ± 0.15 °C for those of PCC, respectively (Table 1).
Production of chitinase, lipase and protease
Both isolates produced chitinase, lipase and protease on solid media; their enzymatic indices are shown in Table 2. Strain P43A produced 1.5-fold more proteases than did strain PCC, while the production of lipases and chitinase was similar for both strains. PCC and P43A were both able to use olive oil or casein as the sole carbon source in the submerged culture. Protease activity was detected 18 h earlier in PCC than in P43A, and the accumulated protease activity was twofold higher in PCC than in P43A. Lipase activity was detected in both strains after 72 h, and PCC produced 1.8-fold more lipases than did P43A. The μ of PCC in casein was 2.4-fold higher than that of P43A, and both isolates grew slowly in olive oil (Table 3).
Lethality of aerial conidia and submerged propagules
Figure 2 shows the temporal changes in mortality of Galleria mellonella larvae treated with the submerged or aerial conidia of P43A and PCC. Under the experimental conditions used, 2 days after exposure of the larvae to the aerial conidia of PCC, 20 % of the larvae population was dead. At this same time point, the other propagules had not yet shown a significant effect. After 4 days, an evident difference between both strains was observed; the PCC spores were more virulent than were the P43A-spores. After 10 days, the difference between the two spore types was smaller. From day 4, a fraction of the larvae treated with PCC aerial conidia was partially covered with mycelia. However, when the submerged propagules were used, the mycelia emerged from a fraction of the larvae starting on day 3. When the aerial conidia of the strain P43A were used, mycosed larvae were observed from day 7 and from day 4 when the submerged conidia were used. Table 4 shows the LT50 values for the aerial and submerged conidia of strains P43A and PCC.
Mortality of the last instar larvae of Galleria mellonella infected with the aerial conidia or the submerged propagules (blastospores + conidia) of Isaria fumosorosea isolates. (open circle) P43A Aerial conidia, (open square) PCC Aerial conidia, (filled circle) P43A Submerged propagules, (filled square) PCC Submerged propagules (the experiments were performed three times)
Discussion
The temperature tolerance of fungal isolates relates to their geographical origins. For example, fungal isolates from the temperate climates of Europe exhibited optimal growth rates at temperatures from 20 to 25 °C. Isolates from the humid or dry subtropical zones of the southern United States or from the humid tropics of western Asia exhibited optimal growth at temperatures between 25 and 28 °C (Cabanillas and Jones 2009; Fargues and Bon 2004; Yeo et al. 2003;). PCC was isolated from a dry tropical region, where the maximal temperature in summer is slightly lower than in the climate from which P43A was obtained. For the PCC strain in the solid culture, the μ increased as the temperature did in the range from 20 to 25 °C and decreased sharply at higher temperatures. For P43A, however, the μ remained fairly constant up to 28 °C (Fig. 1). Moreover, the μ of PCC was higher than that of P43A at temperatures up to 25 °C, but at 32 °C, the μ of PCC was only half that of P43A. Therefore, we conclude that P43A is more tolerant than PCC to high temperatures.
In the submerged culture in SDB-medium, the positive and negative effects of temperature on μ were more notable. Both these two isolates were able to grow in temperatures up to 34 °C (Fig. 1). For both strains, the μ was higher in submerged than in the solid culture, and for P43A at 28 °C, the μ was 22.3-fold higher in submerged than in solid culture. Even in the minimal medium, the μ of both strains at 28 °C was higher in the submerged culture than in the solid culture. Strain P43A grew the fastest, and therefore, its biomass productivity was also the highest. Since the optimal growth temperature for both isolates was 25 °C in the solid culture and 28 °C in the submerged culture, the optimal growth temperature of these isolates is similar to that of the isolates from humid, tropical western Asia (Yeo et al. 2003).
At high temperatures, the net specific growth rate of microorganisms decreases as a result of cell mortality. This decrease is partially due to the denaturation of proteins and other biomolecules and to an increase in the maintenance energy (Gusev et al. 2002). Moreover, we found that temperature affects fungal morphology in the submerged culture. At temperatures less than or equal to the optimal temperature, isolates formed disperse mycelia, and at higher temperatures, the isolates formed pellets. The limited diffusion of nutrients, gases and metabolites into pellets may also account for the decrease in μ at temperatures higher than the optimal temperature (Viniegra-González et al. 2003). For the P43A strain, the decrease in the growth rate as temperature increased was less significant in the solid culture than in the submerged culture (Fig. 1). This result suggests that this isolate is more sensitive to temperature as its growth becomes faster.
It is difficult to compare our data with previously published reports because different culture media, culture conditions and Isaria strains have been used. Asaff et al. (2006) cultivated a strain of I. fumosorosea Pfrd in a minimal medium supplemented with 20 g/l glucose and 7 g/l monosodium glutamate monohydrate at 27 °C. Under these culture conditions, the maximal biomass concentration (Xmax) was 3.85 g/l, while the biomass yield on glucose (Yx/s) was 0.1925 and μmax = 0.114 h−1. When cultured on maltose or glucose as a carbon source, the I. fumosorosea strain 92117 has a μmax = 0.0168 or 0.2647 h−1 respectively, at 28 °C (Vidal et al. 1998). Therefore the μ of strain P43A at 28 °C is higher than that reported for other I. fumosorosea strains.
The aerial conidia produced on rice-agar of both isolates were able to germinate after heating for 30 min at temperatures from 30 to 42 °C, but P43A spores showed the highest thermotolerance (Table 1). Because spores of both isolates were produced under the same conditions, P43A is more thermotolerant than PCC. The tolerance of B. bassiana and Metharizium anisopliae aerial conidia to thermal stress is affected by both the medium and the culture conditions. For example, M. anisopliae aerial conidia produced under conditions of nutritive stress are two times more thermotolerant than conidia produced under nutrient-rich conditions (Rangel et al. 2005, Ying and Feng 2006). The rice-agar medium used in this work has 1 % yeast extract and the incubation temperature was 25 °C; therefore, we suggest that beyond the nutrient limitation, thermotolerance is also a characteristic of the strain.
The concentration of organic nitrogen affected the ratio of blastospores:conidia of other I. fumosorosea isolates in the submerged culture. For example, in a medium with 13.2 g/l casamino acids and 80 g/l glucose, I. fumosorosea strain Mycotech 612 produced a high concentration of biomass and formed predominantly blastospores. However, when the casamino acid concentration was reduced tenfold, a lower biomass concentration was obtained and conidia dominated; this result suggests that the concentration of organic nitrogen favors blastospore production (Cliquet and Jackson 2005; Thomas et al. 1987). Because the minimal medium utilized for production of submerged conidia in this work had only ammonium nitrate as a nitrogen source, it was expected that conidia would dominate; however, the blastospores:conidia ratio was 1:5 for P43A and 1:2 for PCC. Therefore, the blastospore:conidia ratio also depends on the genetic characteristics of the isolate within a species. Submerged conidia are more resistant to high temperatures and more desiccation-resistant than blastospores. They are hydrophilic and germinate faster than aerial conidia; consequently, these conidia could be advantageous for aqueous applications (as blastospores). However, because P43A are especially resistant to high temperatures, they may be more suitable for hot climate regions (Jackson et al. 2010).
The chitinase indices of strains P43A and PCC in the solid culture (Table 2) were higher than those obtained by St. Leger et al. (1997) for strains of V. lecanii, B. bassiana and M. anisopliae. In this culture system, P43A produced 1.5-fold more proteases than PCC. Moreover, the protease index of the first strain was similar to the index of 40 segregants of the unstable prototrophic recombinants originating from the crosses between the strains E6–7 (vio met − bio −) and E6-8 (ylo pyr- lys − ) of M. anisopliae protease-hyperproducers (Valadares-Inglis and Azevedo 1997). We conclude that P43A in the solid culture may be a protease hyperproducer. Nevertheless, in the submerged culture, the protease activity was similar for P43A and PCC strains, and the latter produced more lipases (Table 3). Beyond the culture system, enzyme production is also affected by the culture media and the fungal morphology (Papagianni et al. 2001). Our results indicate that the culture system affects the production of each extracellular enzyme distinctly and that the effect of the culture system on enzyme production is highly strain-dependent.
The LT50 of the PCC aerial conidia for G. mellonella larvae was 4.86 days, which is similar to the LT50 of the aerial conidia of Metarhizium sp. for Schistocerca gregaria adults (4.40 days) (Bateman et al. 1996). The aerial conidia of PCC more quickly killed G. mellonella larvae than did those of P43A. However, P43A produced more proteases in the solid culture than did PCC, and proteases play a crucial role in host penetration because the insect cuticle is about 70 % protein (Ali et al. 2010; Rodríguez-Gómez et al. 2009). In addition, the germination rate is related to infectivity (Jackson et al. 2010), but the germination rate of the aerial conidia of both isolates was the same (90 % of conidia germinated in 5 h). On the other hand, the LT50 values were similar for the aerial and submerged propagules of P43A and the submerged propagules of PCC, but the latter produced more proteases in the submerged culture, and 90 % of the propagules germinated in only 4 h. The LT50 values for the aerial conidia and the submerged propagules of P43A and the submerged propagules of PCC were larger (Table 4). Wang et al. (2005) found that the gene-expression patterns of M. anisopliae growing in root exudate, Manduca sexta cuticle or hemolymph, and in Sabouraud Dextrosa Broth are all different. This result suggests critical differences in transcriptional control during pathogenic and saprophytic growth, involving perception mechanisms, carbon metabolism, proteolysis, cell surface properties, and synthesis of toxic metabolites. Therefore, because pathogenicity is multifactor, bioassays in insects are required to screen fungal entomopathogens; germination rate and enzymatic activities alone are not indicative of pathogenicity.
Because of its high specific growth rate, the conidia:blastospores ratio in liquid culture and the termotholerance of its propagules, the P43A strain was more suitable than the PCC for production in the submerged culture. The PCC strain, however, performed better in the solid culture. Because the TL50 was similar for aerial conidia and submerged propagules of P43A, this strain is promising for development into an aqueous mycoinsecticide for foliar applications in hot climate regions because they are hydrophilic (Jackson et al. 2010; Muñoz et al. 1995). Additional submerged culture is an alternative to reduce the lead time in the fermentation process (Moura Mascarin et al. 2010).
In conclusion, because each isolate performed quite differently in solid or submerged cultures, we propose that the selection criteria for a fungal strain for mycoinsecticide production should include the intended culture system for production of the suitable propagule. The observation of the special thermotolerant characteristics in the P43A isolate should encourage further exploration of microorganism from hot, semiarid regions that are adapted to extreme temperatures and very low humidity.
References
Ali S, Huang Z, Ren S (2009) Media composition influences on growth, enzyme activity, and virulence of the entomopathogen hyphomycete Isaria fumosoroseus. Entomol Exp Appl 13:30–38. doi:10.1111/j.1570-7458.2009.00833.x
Ali S, Huang Z, Ren S (2010) Production of cuticle degrading enzymes by Isaria fumosorosea and their evaluation as biocontrol agent against diamondback moth. J Pest Sci 83:361–370. doi:10.1007/s10340-010-0305-6
Asaff A, Cerda-García-Rojas CM, Viniegra-González G, de la Torre M (2006) Carbon distribution and redirection of metabolism in Paecilomyces fumosoroseus during solid-state and liquid fermentations. Process Biochem 4:1303–1310. doi:10.1016/j.procbio.2006.01.001
Bateman R, Carey M, Batt D, Prior C, Abraham Y, Moore D, Jenkins N, Fenlon J (1996) Screening for virulent isolates of entomopathogenic fungi against the desert locust, Schistocerca gregaria (Forskål). Biocontrol Sci Tech 6:549–560
Berekaa MM, Zaghloul TI, Abdel-Fattah YR, Saeed HM, Sifour M (2009) Production of a novel glycerol-inducible lipase from thermophilic Geobacillus stearothermophilus strain-5. World J Microbiol Biotechnol 25:287–294. doi:10.1007/s11274-008-9891-3
Brand D, Soccol CR, Sabu A, Roussos S (2010) Production of fungal biological control agents through solid state fermentation: a case study on Paecilomyces lilacinus against root-knot nematodes. Micol Appl Int 22:31–48
Cabanillas HE, Jones WA (2009) Effects of temperature and culture media on vegetative growth of an entomopathogenic fungus Isaria sp. (Hypocreales: Clavicipitaceae) naturally affecting the whitefly. Bemisia tabaci in Texas. Mycopathologia 167:263–271. doi:10.1007/s11046-008-9176-2
Cliquet S, Jackson MA (2005) Impact of carbon and nitrogen nutrition on the quality, yield and composition of blastospores of the bioinsecticidal fungus Paecilomyces fumosoroseus. J Ind Microbiol Biotechnol 32:204–210. doi:10.1007/s10295-005-0232-3
de Faria MR, Wraight SP (2007) Mycoinsecticides and Mycoacaricides: a comprehensive list with worldwide coverage and international classification of formulation types. Biol Control 43:237–256. doi:10.1016/j.biocontrol.2007.08.001
El-Sayed GN, Ignoffo CM, Leathers TD, Gupta SC (1993) Effects of cuticle source and concentration on expression of hydrolytic enzymes by an entomophatogenic fungus, Nomuraea rileyi. Mycopathologia 122:149–152
Esteves I, Peteira B, Powers S, Magan N, Kerry BR (2009) Effects of osmotic and matric potential on radial growth and accumulation of endogenous reserves in three isolates of Pochonia chlamydosporia. Biocontrol Sci Tech 19:185–199. doi:10.1080/09583150802650175
Fargues J, Bon MC (2004) Influence of temperature preferences of two Paecilomyces fumosoroseus lineages on their co-infection pattern. J Invertebr Pathol 87:94–104. doi:10.1016/j.jip.2004.07.001
Fernandes ÉKK, Bittencourt VREP, Roberts DW (2012) Perspectives on the potential of entomopathogenic fungi in biological control of ticks. Exp Parasitol 130:300–305. doi:10.1016/j.exppara.2011.11.004
García-Carreño FL, Hernández-Cortés MP, Haard NF (1994) Enzymes with peptidase and proteinase activity from the digestive systems of a freshwater and a marine decapot. J Agric Food Chem 42:1456–1461. doi:10.1021/jf00043a013
Gusev NB, Bogatcheva NV, Marston SB (2002) Structure and properties of small heat shock proteins (sHsp) and their interaction with cytoskeleton proteins. Biochem Moscow 67:613–623
Hankin L, Anagnostakis SL (1975) The use of solid media for detection of enzyme production by fungi. Mycologia 67:597–607
Hegedus DD, Khachatourians GG (1988) Production of an extracellular lipase by Beauveria bassiana. Biotechnol Lett 10:637–642
Howard AFV, N′Guessan R, Koenraadt CJM, Asidi A, Farenhorst M, Akogbéto M, Knols BGJ, Takken W (2011) First report of the infection of insecticide-resistant malaria vector mosquitoes with an entomopathogenic fungus under field conditions. Malar J 10:1–8
Imoulan A, Alaoui A, El Meziane A (2011) Natural occurrence of soil-borne entomopathogenic fungi in the Moroccan Endemic forest of Argania spinosa and their pathogenicity to Ceratitis capitata. World J Microbiol Biotechnol 27:2619–2628. doi:10.1007/s11274-011-0735-1
Jackson MA, Dunlap CA, Jaronski ST (2010) Ecological considerations in producing and formulating fungal entomopathogens for use in insect biocontrol. Biocontrol 55:129–145. doi:10.1007/s10526-009-9240-y
Jaronski ST (2010) Ecological factors in the inundative use of fungal entomopathogens. Biocontrol 55:159–185. doi:10.1007/s10526-009-9248-3
Kalbfleisch JG (1985) Probability and statistical inference II. Springer, New York
Lacey LA, Wraight SP, Kirk AA (2008) Entomopathogenic fungi for control of Bemisia tabaci biotype B: foreign exploration, research and implementation. Prog Biol Control 4:33–69
Miyashira CH, Tanigushi DG, Gugliotta AM, Santos DYAC (2010) Comparison of radial growth rate of the mutualistic fungus of Atta sexdens rubropilosa forel in two culture media. Braz J Microbiol 41:506–511
Montesinos-Matías R, Viniegra-González G, Alatorre-Rosas R, Loera O (2011) Relationship between virulence and enzymatic profiles in the cuticle of Tenebrio molitor by 2-deoxy-d-glucose-resistant mutants of Beauveria bassiana (Bals.) Vuill. World J Microbiol Biotechnol 27:2095–2102. doi:10.1007/s11274-011-0672-z
Moura Mascarin G, Batista Alves S, Biaggioni Lopes R (2010) Culture media selection for mass production of Isaria fumosorosea and Isaria farinosa. Braz Arch Biol Technol 53:753–761
Muñoz GA, Agosin E, Cotoras M, Martin RS, Volpe D (1995) Comparison of aerial and submerged spore properties for Trichoderma harzianum. FEMS Microbiol Lett 125:63–69
Nieto TP, Ellis AE (1986) Characterization of extracellular metallo- and serine-proteases of Aeromonas hydrophila strain B51. J Gen Microbiol 132:1975–1979. doi:10.1099/00221287-132-7-1975
Papagianni M, Nokes SE, Filer K (2001) Submerged and solid-state phytase fermentation by Aspergillus niger: effects of agitation and medium viscosity on phytase production, fungal morphology and inoculum performance. Food Technol Biotech 39:319–326
Pogori N, Cheikhyoussef A, Xu Y, Wang D (2008) Production and biochemical characterization of an extracellular lipase from Rhizopus chinensis CCTCC M201021. Biotechnology 7:710–717
Rangel DEN, Braga GUL, Anderson AJ, Roberts DW (2005) Variability in conidial thermotolerance of Metarhizium anisopliae isolates from different geographic origins. J Invertebr Pathol 88:116–125
Rodríguez-Gómez OL, Saucedo-Castañeda G, Viniegra-González G (2009) Substrate influence on physiology and virulence of Beauveria bassiana acting on larvae and adults of Tenebrio molitor. World J Microbiol Biotechnol 25:513–518. doi:10.1007/s11274-008-9917-x
Shoaib F, Feng-Liang J, Shun-Xiang R (2011) Determination of genetic variability among the isolates of Metarhizium anisopliae var. anisopliae from different geographical origins. World J Microbiol Biotechnol 27:359–370. doi:10.1007/s11274-010-0466-8
St. Leger RJ, Joshi L, Roberts DW (1997) Adaptation of proteases and carbohydrases of saprophytic, phytopathogenic and entomopathogenic fungi to the requirements of their ecological niches. Microbiology 143:1983–1992
Tefera T, Pringle KL (2003) Effect of exposure method to Beauveria bassiana and conidia concentration on mortality, mycosis, and sporulation in cadavers of Chilo partellus (Lepidoptera: Pyralidae). J Invertebr Pathol 84:90–95
Thomas KC, Khachatourians GG, Ingledew WM (1987) Production and properties of Beauveria bassiana conidia cultivated in submerged culture. Can J Microbiol 33:12–20
Valadares-Inglis MC, Azevedo JL (1997) Amylase and protease secretion in recombinant strains of Metarhizium anisopliae var. anisopliae following parasexual crosses. Brazil J Genet 20:171–175
Vega FE, Jackson MA, Mercadier G, Poprawski TJ (2003) The impact of nutrition on spore yields for various fungal entomopathogens in liquid culture. World J Microbiol Biotechnol 19:363–368
Vidal C, Fargues J, Lacey LA, Jackson MA (1998) Effect of various liquid culture media on morphology, growth, propagule production, and pathogenic activity to Bemisia argentifolii of the entomopathogenic Hyphomycete, Paecilomyces fumosoroseus. Mycopathologia 143:33–46
Viniegra-González G, Favela-Torres E, Aguilar CN, Rómero-Gomez SJ, Díaz-Godínez G, Augur C (2003) Advantages of fungal enzyme production in solid state over liquid fermentation systems. Biochem Eng J 13:157–167
Wang C, Hu G, St Leger RJ (2005) Differential gene expression by Metarhizium anisopliae growing in root exudate and host (Manduca sexta) cuticle or hemolymph reveals mechanisms of physiological adaptation. Fungal Genet Biol 42:704–718
Wraight SP, Inglis GD, Goettel MS (2007) Overview of pathogen groups: Fungi. In: Lacey LA, Kaya HK (eds) Field manual of techniques in invertebrate pathology, 2nd edn. Springer, Dordrecht, pp 223–248
Yeo H, Pell JK, Alderson PG, Clark SJ, Pye BJ (2003) Laboratory evaluation of temperature effects on the germination and growth of entomopathogenic fungi and on their pathogenicity to two aphid species. Pest Manag Sci 59:156–165. doi:10.1002/ps.622
Ying SH, Feng MG (2006) Medium components and culture conditions affect the thermotolerance of aerial conidia of fungal biocontrol agent Beauveria bassiana. Lett Appl Microbiol 43:331–335. doi:10.1111/j.1472-765X.2006.01947.x
Zibaee A, Sadeghi-Sefidmazgi A, Fazeli-Dinan M (2011) Properties of a lipase produced by Beauveria bassianna: purification and biochemical studies. Biocontrol Sci Techn 2:317–331. doi:10.1080/09583157.2010.548595
Acknowledgments
We thank the Department of Chemical Engineering at the University of Sonora and the PROMEP UNISON-279 for supporting this work.
Author information
Authors and Affiliations
Corresponding author
Rights and permissions
About this article
Cite this article
Esther, CP., Erika, AS., Rosa María, MC. et al. Performance of two isolates of Isaria fumosorosea from hot climate zones in solid and submerged cultures and thermotolerance of their propagules. World J Microbiol Biotechnol 29, 309–317 (2013). https://doi.org/10.1007/s11274-012-1184-1
Received:
Accepted:
Published:
Issue Date:
DOI: https://doi.org/10.1007/s11274-012-1184-1